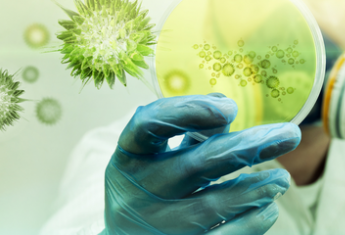

Сообщалось, что на вечер 22 апреля в Херсонской области было зафиксировано уже 77 лабораторно подтвержденных случаев заболевания COVID-19, из которых 1 летальный в Олешковской районе, 10 человек полностью выздоровели.
За последние сутки зафиксировано 5 новых случаев: Это 3 человека из Олешковского района (мужчины 32 и 42 лет, ребенок 8 лет, все на самоизоляции), мужчина 66 лет из Голопристанского района (в Херсонской областной инфекционной больнице), ребенок 11 лет в больнице Новой Каховки
На утро 23 апреля цифры не поменялись. География распространения коронавирусной инфекции на территории Херсонщины:
Белозерский район - 1 случай;
Геническ - 3 случая;
Голопристанский район - 13 случаев;
Новая Каховка - 7 случаев;
Нововоронцовский район - 1 случай;
Олешковский район - 41 случай;
Херсон - 10 случаев;
Чаплинский район - 1 случай.

Добавить комментарий